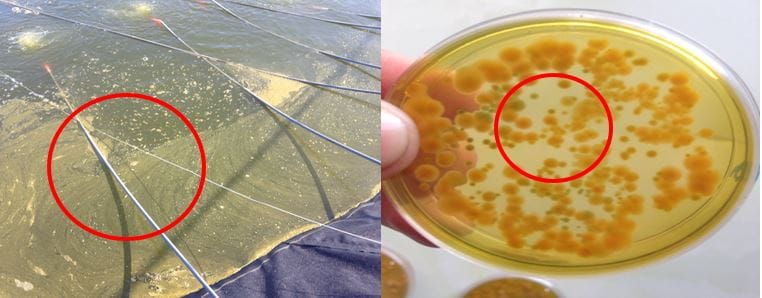

TÔM BỊ NỘI NGOẠI KÍ SINH TRÙNG GÂY XOẮN RUỘT, RUỘT LỎNG, MỦ ĐUÔI VÀ CÁCH KHẮC PHỤC
Trong ngành nuôi trồng thủy sản, đặc biệt là nuôi tôm và cá tại Việt Nam, một trong những thách thức lớn mà người nuôi đang phải đối mặt là các vấn đề liên quan đến dịch bệnh và kí sinh trùng. Sự bùng phát của các dịch bệnh không chỉ làm giảm năng suất mà còn ảnh hưởng đến chất lượng của sản phẩm. Đặc biệt, các loài kí sinh trùng, cả nội và ngoại, là một trong những nguyên nhân gây bệnh phổ biến trên tôm và cá, làm suy yếu hệ thống miễn dịch và khiến chúng dễ mắc các bệnh khác. Để đối phó với vấn đề này, một giải pháp đã được áp dụng hiệu quả là sử dụng thuốc trị kí sinh trùng. Một trong những sản phẩm được đánh giá cao là Ivermectin, được biết đến qua tên thương mại là Ivermax. Tình trạng tôm bị ruột xoắn, ruột lỏng và mủ đuôi có thể xảy ra ở tất cả các giai đoạn nuôi (thường tập trung nhiều nhất là vào khoảng 20 – 60 ngày tuổi).
Ảnh ký sinh Vermiform (bên trái) và ký sinh trùng Gregarine (bên phải) trên tôm
1. Nguyên nhân làm tôm bị xoắn ruột, ruột lỏng, mủ đuôi
- Tôm bị nội ngoại kí sinh trùng do các nhóm vi khuẩn Vibrio (V. Harveyi, V. vulnificus,..) gây bệnh trên tôm
- Trùng 2 tế bào (Vermiform, Gregarine,..)
- Tôm bị nhiễm bệnh từ môi trường: Nấm, tảo độc (tảo lam, tảo giáp,..), đáy ao nuôi dơ, lợn cợn,..
- Thời tiết giao mùa (tháng 6 đến tháng 8), mưa kéo dài sau đó nắng gắt cũng là một trong những nguyên nhân làm tôm bị ruột xoắn, ruột lỏng, mủ đuôi.
Ảnh xác tảo tàn (bên trái) và khuẩn nước cao trong ao tôm (bên phải)
2. Dấu hiệu nhận biết tôm bị ruột xoắn, ruột lỏng, mủ đuôi
- Cảm quan bên ngoài ruột tôm có hình dạng xoắn lò xo.
- Tôm giảm ăn 30-50%
- Ruột tôm bị lỏng hay còn gọi là “chạy ruột”
- Phần cuối ruột tôm (trên hậu môn) xuất hiện mủ đuôi màu trắng (hạt gạo)
- Gan tôm vàng mờ nhạt, tôm bị nặng có thể biến chứng teo gan.
Tình trạng tôm bị ruột xoắn và đường ruột lỏng
3. Hậu quả tôm bị ruột xoắn, ruột lỏng, mủ đuôi
- Khi tôm bị nội ngoại kí sinh trùng đường ruột tôm bị hư hoại, lông mao đường ruột không phát triển.
- Ruột tôm lỏng, đứt khúc và mất ruột.
- Tôm ốp thân, còi cọc, chậm lớn và hao lát đát liên tục trong thời gian dài.
- Quá trình bệnh kéo dài, không khắc phục sẽ dẫn đến tôm bị phân trắng.
Tôm bị mất ruột (bên trái) và lông mao đường ruột tôm kém phát triển (bên phải)
Mặc dù tình trạng tôm bị ruột xoắn, ruột lỏng và mủ đuôi không gây chết tôm đồng loạt nhưng nó lại ảnh hưởng trực tiếp đến đường ruột tôm, làm tôm giảm tiêu hóa, giảm hấp thu, từ đó làm cho tốc độ phát triển của tôm. Thế nên, việc phòng trị bệnh ruột xoắn, ruột lỏng và mủ đuôi cho tôm là điều rất cần thiết.
4. Cách khắc phục tình trạng tôm bị ruột xoắn, ruột lỏng, mủ đuôi
Bước 1: Vào 3 ngày đầu trộn cho ăn INVE MAX với liều lượng 3-6ml/kg thức ăn
Bước 2: Thay nước 50% vào lúc chiều mát và diệt khuẩn, nấm bằng CN9000. Thực hiện lúc 9-10 giờ sáng với liều lượng 1l CN9000 cho 3000m3 nước ao.
Bước 3 : Sau 2 ngày gây màu nước lại bằng Vi sinh Ultimate Cleaner và Vi sinh Super Bio để xử lý đáy & khí độc trong ao, triệt tiêu hoàn toàn Vi khuẩn gây bệnh
Trên đây là nguyên nhân, dấu hiệu nhận biết và cách điều trị tôm bị ruột xoắn, ruột lỏng, mủ đuôi, mọi thắc mắc về kỹ thuật hay thông tin sản phẩm trong bài, bà con vui lòng liên hệ qua Hotline 0976.412.348 để được các kỹ thuật viên của công ty trực tiếp giải đáp.
KỸ THUẬT NAM HẢI DƯƠNG